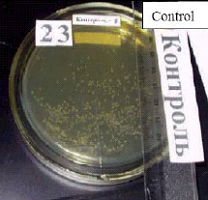
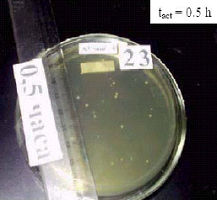
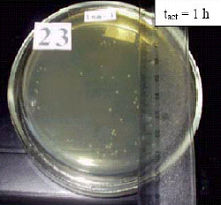
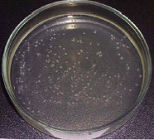
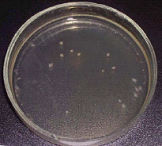
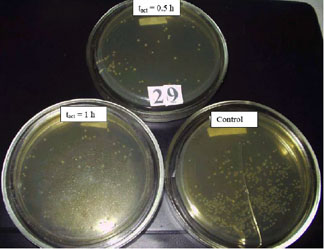

CORE_REFERENCE // ARTICLE_VIEW
Biologische Testergebnisse
lang: delesen: 28 minaktualisiert: 2025.08.08
MRET AKTIVIERTES WASSER UND SEINE ERFOLGREICHE ANWENDUNG ZUR PRÄVENTIVEN BEHANDLUNG UND VERBESSERTEN TUMORRESISTENZ IN DER ONKOLOGIE
Das Ziel dieser Untersuchung war es, an Mäusen den Effekt von MRET aktiviertem Wasser als potenzielles Mittel zur Prävention und Behandlung zweier Arten onkologischer Erkrankungen (Labormodelle von Ehrlichs Aszites‑Tumor und Sarkom, Aszites‑Form) zu studieren. Ein signifikanter positiver Effekt von MRET aktiviertem Wasser auf die Tumorresistenz von Tieren wurde in Experimenten an 500 Mäusen beobachtet (22 Gruppen mit je 20 Mäusen und 10 Gruppen mit je 5 Mäusen). Die besten Ergebnisse wurden in den Gruppen von Mäusen erzielt, die MRET Wasser aktiviert für 30 Minuten (optimales Aktivierungsregime) tranken. Die erhebliche antitumorale Wirksamkeit wurde bestätigt durch eine sehr hohe Reduktion der Gesamtzahl lebensfähiger Tumorzellen um 76% in der «präventiven Behandlung» und um 55% im «therapeutischen Behandlung»-Regime. Die Lebensspanne der Mäuse, die optimal aktiviertes Wasser erhielten, erhöhte sich um 61% in der «präventiven Behandlung» und um 43% im «therapeutischen Behandlung»-Regime. Der signifikante antitumorale Effekt von MRET aktiviertem Wasser auf Mäuse war vergleichbar mit der Wirkung von Chemotherapeutika und erlaubte es, die Nebenwirkungen zu vermeiden, die typischerweise einer Chemotherapiebehandlung in der Onkologie folgen.
Abb. 1: Der Effekt präventiver (1–5) und therapeutischer (6–10) Anwendung von MRET aktiviertem Wasser auf die durchschnittliche Gesamtzahl lebensfähiger Zellen <C> in einem Aszites‑Tumor, gewonnen von Mäusen mit intraperitoneal inokulierten Tumorzellen von Ehrlich‑Karzinom.
Abb. 2: Die Änderung des prozentualen Anstiegs der Lebensspanne von tumorbehafteten Mäusen mit Aszites‑Ehrlich‑Karzinom, die verschiedene Typen von MRET aktiviertem Wasser in «präventiver Behandlung» und «therapeutischer Behandlung»-Regimen erhielten. Die Ziffern unter den Diagrammen entsprechen der Dauer der Wasseraktivierung in Minuten.
Abb. 3: Der Effekt von MRET aktiviertem Wasser auf die zytotoxische Aktivität von Lymphozyten, die NK‑Zellen enthalten. Aktiviertes Wasser wurde bei Mäusen ohne Tumoren in zwei Regimen angewandt (für 21 und 14 Tage), bezeichnet als «präventiv» (1–5) und «therapeutisch» (6–10).
Foto: Das Erscheinungsbild von Mäusen aus «Kontroll»‑ (A) und «präventiv behandelten» Gruppen (optimale Aktivierungszeit 30 Minuten) (B) am 18. Tag nach der Inokulation von Aszites‑Ehrlich‑Karzinom‑Zellen.
Die Ergebnisse der Untersuchung der Anwendung von Wasser, das durch die nicht‑ionisierende Molecular Resonance Effect Technology (MRET) aktiviert wurde, zur Präventionsbehandlung und zur Verbesserung der Tumorresistenz von Tieren gegenüber zwei Arten onkologischer Erkrankungen in vivo an 500 Mäusen werden präsentiert. Die an physikalischen Parametern von Wasser durchgeführte Forschung bestätigte, dass der MRET‑Aktivierungsprozess zu substantiellen Modifikationen der grundlegenden physikalisch‑molekularen Eigenschaften von destilliertem Wasser beitrug (erhebliche Reduktion der Viskosität als Funktion angelegter Schubspannung sowie erhebliche Abnahme der elektrischen Leitfähigkeit und Dielektrizitätskonstante als Funktionen der angelegten elektromagnetischen Feldfrequenzen). Der signifikante positive Effekt von MRET aktiviertem Wasser auf die Tumorresistenz von Tieren wurde im Verlauf dieser Untersuchung in allen Gruppen von Mäusen mit verschiedenen Fraktionen von aktiviertem Wasser beobachtet. Die besten Ergebnisse wurden in den Gruppen von Mäusen erzielt, die MRET Wasser aktiviert für 30 Minuten (optimales Aktivierungsregime) tranken. Die Ergebnisse waren im «präventiven Behandlung»‑Regime besser als im «therapeutischen Behandlung»‑Regime. Zusätzlich bestätigte diese Untersuchung, dass die Langzeitlagerung von aktiviertem Wasser bei niedriger Temperatur (um 0°C) für 45 Tage seine antitumorale Wirksamkeit verringerte, aber sie auf einem signifikant hohen Niveau im Vergleich zu anderen Fraktionen belassen hat. Die Testergebnisse weisen auf einen dualen Mechanismus der MRET‑Wasserwirkung auf Tumoren hin: die Prävention und Hemmung des Tumorwachstums zusammen mit der Reduktion der Anzahl lebensfähiger Tumorzellen. Der signifikante antitumorale Effekt von MRET aktiviertem destilliertem Wasser auf Mäuse war vergleichbar mit der Wirkung von Chemotherapeutika und erlaubte es, die Nebenwirkungen zu vermeiden, die typischerweise einer Chemotherapiebehandlung in der Onkologie folgen.
Im Verlauf der Untersuchung der zytotoxischen Aktivität von NK‑Zellen wurde eine signifikante Erhöhung der zytotoxischen Lymphozytenaktivität beobachtet, wenn Spender‑Mäuse mit MRET Wasser behandelt wurden, das für 30 Minuten aktiviert war. Die Ergebnisse zeigten auch, dass die Verlängerung der Anwendung von MRET Wasser von 14 Tagen auf 21 Tage den Wert des Zytotoxizitätsindex signifikant erhöhte. Es ist möglich anzunehmen, dass die Verlängerung der Anwendungszeit von MRET Wasser zu höheren Niveaus der Verbesserung der NK‑Zell‑Aktivität führen wird. Somit kann die Anwendung von MRET aktiviertem Wasser ein ziemlich vielversprechender Ansatz zur nicht‑medikamentösen Stimulation von NK‑Zell‑Impfstoffen sein.
Die detaillierte Beschreibung dieser Untersuchung ist in «VORTEILE VON MRET WATER» dargestellt.
_______________________________________________________________________________________________
DER EFFEKT VON MRET AKTIVIERTEM MEDIUM AUF DIE ZELLMORPHOLOGIE
Die in vitro Untersuchungen an normalen PMBC‑Zellen (periphere mononukleäre Blutzellen) und an HeLa‑Krebszellen (Zelllinie ATCC # CCL‑2 Zervixadenokarzinom) wurden unter der Aufsicht von Patrick Pezzoli, Ph.D. bei AltheaDx Technologies, San Diego, USA durchgeführt. Die Experimente analysierten: Zellen, die bei 0 Stunden lysiert wurden, Zellen, die 24 Stunden in unbehandeltem Medium kultiviert wurden, und Zellen, die 24 Stunden in Medium kultiviert wurden, das mit MRET‑Aktivator für 30 Minuten behandelt wurde. DNA‑Proben aus jeder Charge wurden verarbeitet und die resultierenden Daten wurden mit Affymetrix Genotyping Console 3.0 analysiert, um Genotyp‑Aufrufe und Copy‑Number‑Aufrufe zu erhalten. Zellzählungen und %‑Viabilität wurden mit der Trypan‑Blau‑Ausschlusstechnik ermittelt.
Die experimentellen Daten zeigten keinen Unterschied zwischen der Nullstunde (Kontrolle), MRET‑behandelten und unbehandelten Proben in Bezug auf Genotypen und Copy‑Number‑Aufrufe. Somit induzierte die MRET‑Aktivierung von wasserbasiertem Medium keine Veränderungen in Zellen auf genetischer Ebene.
Die Studien zeigten, dass in MRET‑aktiviertem Medium die Viabilität normaler Zellen (PBMC) höher war (Tabelle 1) und die Viabilität von Krebszellen (HeLa) niedriger war (Tabelle 2) im Vergleich zu ihrer Viabilität in unbehandeltem Medium.
Tabelle 1: PBMC‑Zellzählungen und %‑Viabilität
| Probe | Zellzahl | % Viabilität | Lebensfähige Zellen |
| 0 Stunden | 3,27x106 | 91,5 | 2,99x106 |
| Unbehandelt | 8,70x105 | 83,4 | 0,73x106 |
| Behandelt | 7,73x105 | 88,8 | 0,69x106 |
Tabelle 2: HeLa‑Zellzählungen und %‑Viabilität
| Probe | Zellzahl | % Viabilität | Lebensfähige Zellen |
| 0 Stunden | 3x106 | 92 | 3,27x106 |
| Unbehandelt | 7x106 | 97 | 6,79x106 |
| Behandelt | 5x106 | 92 | 4,60x106 |
Für normale Zellen (PBMC) waren die Änderungen in den Zellzählungen ähnlich für unbehandeltes und MRET‑behandeltes Medium (Abb. 1). Somit beeinflusste die MRET‑Behandlung nicht das Wachstum normaler Zellen.
Für Krebszellen (HeLa) zeigten die experimentellen Daten eine signifikante Hemmung des Wachstums von Krebszellen in MRET‑behandeltem Medium. Das Wachstum lebensfähiger Krebszellen wurde um 54% in MRET‑behandeltem Medium im Vergleich zu unbehandeltem Medium gehemmt (Abb. 2).
Abb. 1: Lebensfähige PBMC‑Zellzählungen nach 24 Stunden Inkubation Abb. 2: Lebensfähige HeLa‑Zellzählungen nach 24 Stunden Inkubation
Die Ergebnisse der AltheaDx‑Forschung an HeLa‑Krebszellen in vitro unterstützen die Ergebnisse, die früher in der Untersuchung bezüglich der Effekte von MRET Wasser auf Tumorresistenz im Tiermodell erhalten wurden. Die Studie an 500 Mäusen wurde unter der Aufsicht von Professor V. Vysotskii, S. Olishevsky, Ph.D. und Y. Yanish, Ph.D. am Kiewer Institut für Experimentelle Pathologie, Onkologie und Radiobiologie der Ukrainischen Akademie der Wissenschaften durchgeführt. Sie zeigte eine erhebliche Hemmung des Wachstums lebensfähiger Tumorzellen nach dem Konsum von MRET Wasser. Im Verlauf dieser Untersuchung nahmen die Gruppen von Mäusen im «präventiven Regime» MRET Wasser für 2 Wochen vor der Inokulation von Ehrlich‑Karzinom‑Krebszellen und für 3 Wochen nach der Inokulation zu sich. Die Gruppen von Mäusen im «therapeutischen Regime» nahmen MRET Wasser nur während 3 Wochen nach der Inokulation von Ehrlich‑Karzinom‑Krebszellen zu sich. Nach dem Konsum von MRET Wasser, das für 30 Minuten aktiviert war (die optimale Aktivierungszeit), wurde das Wachstum lebensfähiger Tumorzellen um 76% im «präventiven Regime» und um 55% im «therapeutischen Regime» gehemmt.
Abb. 1: Lebensfähige PBMC‑Zellzählungen nach 24 Stunden Inkubation Abb. 2: Lebensfähige HeLa‑Zellzählungen nach 24 Stunden Inkubation
Die Ergebnisse der AltheaDx‑Forschung an HeLa‑Krebszellen in vitro unterstützen die Ergebnisse, die früher in der Untersuchung bezüglich der Effekte von MRET Wasser auf Tumorresistenz im Tiermodell erhalten wurden. Die Studie an 500 Mäusen wurde unter der Aufsicht von Professor V. Vysotskii, S. Olishevsky, Ph.D. und Y. Yanish, Ph.D. am Kiewer Institut für Experimentelle Pathologie, Onkologie und Radiobiologie der Ukrainischen Akademie der Wissenschaften durchgeführt. Sie zeigte eine erhebliche Hemmung des Wachstums lebensfähiger Tumorzellen nach dem Konsum von MRET Wasser. Im Verlauf dieser Untersuchung nahmen die Gruppen von Mäusen im «präventiven Regime» MRET Wasser für 2 Wochen vor der Inokulation von Ehrlich‑Karzinom‑Krebszellen und für 3 Wochen nach der Inokulation zu sich. Die Gruppen von Mäusen im «therapeutischen Regime» nahmen MRET Wasser nur während 3 Wochen nach der Inokulation von Ehrlich‑Karzinom‑Krebszellen zu sich. Nach dem Konsum von MRET Wasser, das für 30 Minuten aktiviert war (die optimale Aktivierungszeit), wurde das Wachstum lebensfähiger Tumorzellen um 76% im «präventiven Regime» und um 55% im «therapeutischen Regime» gehemmt.
Als Schlussfolgerung kann gesagt werden, dass die bei AltheaDx Technology durchgeführten Studien bestätigten, dass MRET aktiviertes Wasser die Zellen auf genetischer Ebene nicht beeinflusste; es beeinflusste die Morphologie normaler Zellen auf positive Weise, indem es ihre Viabilität erhöhte, und förderte eine signifikante Hemmung des Wachstums von Krebszellen.
_______________________________________________________________________________________________
MRET REBOUNDING‑EFFEKT AUF DIE LEUKOZYTENZAHL
Eine klinische Beobachtung wurde an einem Patienten durchgeführt, der sich einer Chemotherapiebehandlung für metastasiertes Nasopharynxkarzinom unterzog. Regelmäßig sinken die WBC‑Zahlen normalerweise auf ein sehr niedriges Niveau. Das Wiederanstiegen der WBC von diesem niedrigen Bereich dauert etwa 3‑5 Wochen. Die Einnahme von MRET Wasser verhinderte das Absinken der WBC‑Zahlen auf ihr niedrigstes Niveau und half dabei, das prä‑Chemotherapie‑Niveau innerhalb einer ungewöhnlich kurzen Zeit von 3 Tagen wiederzuerlangen.
Somit zeigte die klinische Beobachtung, dass am 10. Tag nach Beginn der Chemotherapie (3 Tage nachdem die WBC‑Zahlen auf 10% des prä‑Chemotherapie‑Niveaus gesunken waren) die WBC‑Zahlen auf 93% ihres prä‑Chemotherapie‑Niveaus wiederanstiegen. In Übereinstimmung mit den Student‑Verteilungskriterien war das Wiederanstiegen der WBC höher als 70% des prä‑Chemotherapie‑Niveaus mit p=0,05.
_______________________________________________________________________________________________
ANTIBAKTERIELLER EFFEKT VON MRET WASSER
Tests, die bei C.A.I. Environmental Laboratory, Carlsbad, USA durchgeführt wurden, zeigten eine signifikante Reduktion der Gesamtmenge an Koliformen nach dem MRET‑Aktivierungsprozess. Im Regenwasser, das für 30 Minuten aktiviert wurde, verringerte sich die Menge an Gesamtkoliformen um 86% nach dem Wasseraktivierungsprozess. Dieser Test bestätigt, dass MRET Wasser als antibakterielles Mittel wirkt und einen Sterilisationseffekt bietet.
_______________________________________________________________________________________________
Der Effekt von MRET aktiviertem Wasser auf Escherichia coli K‑12 und auf komplexe mikrobiologische Assoziationen
Die Forschung wurde am Kiewer Institut für Mikrobiologie und Virologie der Ukrainischen Akademie der Wissenschaften durchgeführt.
I. MRET aktiviertes Wasser hemmender Effekt auf das Wachstum von bedingt pathogenen Bakterien Escherichia coli K‑12 in aerober Umgebung
Die Untersuchung zeigte den signifikanten Effekt von MRET‑aktiviertem Nährmedium in aerober Umgebung auf den Prozess des Wachstums und der Vermehrung von E.coli‑Mikroorganismen, ihre Teilung, die Größe der Kolonien und die Modifikation der Formen von Kulturzellen. Es wurde beobachtet, dass bei niedriger Anfangskonzentration von Zellen der untersuchten Kultur Escherichia coli K‑12 MRET‑Nährmedium, das während 30 Minuten und 60 Minuten aktiviert wurde, das Wachstum der Kultur 27 und 303 Mal während der 25 Stunden des Experiments hemmte.
Die anfängliche Ansicht von Petrischalen mit verschiedenen Fraktionen von Nährmedium zu Beginn des Experiments ist in Abb. 1 dargestellt.
Abb. 1: Petrischalen zu Beginn des Experiments. Identische sehr kleine Mengen von Escherichia coli K‑12‑Zellen wurden auf die Oberfläche von nicht‑aktiviertem Nährmedium der Kontrollschalen und auf die Oberfläche von Schalen mit Nährmedium, das MRET‑aktiviert für 30 und 60 Minuten (tact=0,5h und tact=1,0h) in aerober Umgebung war, aufgebracht. Es gibt keine Kolonien von Mikroorganismen in den Petrischalen zu Beginn des Experiments.
Petrischalen mit gewachsenen Kolonien und statistische Parameter der Kolonien nach 23 Stunden Experimenten sind in Abb. 2 dargestellt: (a) nicht‑aktiviertes Nährmedium (Kontrolle); (b) Nährmedium aktiviert für 30 Minuten; (c) Nährmedium aktiviert für 60 Minuten. Petrischalen nach 29 Stunden Experiment sind in Abb. 3 gezeigt. Die signifikante Hemmung des Wachstums von E.coli in aktivierten Proben wurde aufgedeckt und bestätigte den starken bakteriostatischen Effekt von MRET‑aktiviertem Medium.
|
|
| (a) Kontrolle: Anzahl der Kolonien NC = 1,7x108 CFU/ml. Durchschnittlicher Durchmesser der gewachsenen Kolonien d = 1,1 mm. |
(b) MRET‑aktiviert, tact = 30 Minuten: Anzahl der Kolonien N0,5 = 6,4x106 CFU/ml. Durchschnittlicher Durchmesser der gewachsenen Kolonien d = 1,8 mm. |
|
|
| (c) MRET‑aktiviert, tact = 60 Minuten: Anzahl der Kolonien N1,0 = 5,2x105 CFU/ml. Durchschnittlicher Durchmesser der gewachsenen Kolonien ist d = 1,5 mm. |
Abb. 2: Petrischalen nach 23 Stunden Experiment. |
|
|
| Abb. 3: Ausgewählte Petrischalen mit gewachsenen Kolonien von E.coli K‑12 nach 29 Stunden Experiment. |
Dieses Experiment zeigt, dass der MRET‑Aktivierungsprozess einen sehr starken bakteriostatischen Effekt auf bedingt pathogene E.coli‑Mikroorganismen hat und dass die Hemmung des E.coli‑Wachstums effektiver ist, wenn die Aktivierungszeit erhöht wird. Es wurde beobachtet, dass bei niedriger Anfangskonzentration von Zellen von E.coli in Nährmedium MRET‑Aktivierung während 30 Minuten und 60 Minuten Zeitraum das Wachstum der Kultur NC/N0,5 = 27 und NC/N1,0 = 303 Mal während der 25 Stunden des Experiments hemmte. Folglich war das Niveau der bakteriostatischen Aktivität 96% in 30 Minuten aktiviertem Nährmedium und 99,7% in 60 Minuten aktiviertem Medium. Somit wurde die direkte Korrelation zwischen der bakteriostatischen Aktivität von MRET‑aktiviertem Nährmedium und der Aktivierungszeit bestätigt.
Hemmung des E.coli‑Bakterienwachstums in aerober Umgebung
Abb. 4: Die Hemmung des E.coli‑Wachstums in aerober Umgebung: 303 Mal (tact=1,0 Stunde) und 27 Mal (tact=0,5 Stunde) nach 25 Stunden Experiment (blaue Farbe — Kontrolle, rot — 30 Minuten und grün — 60 Minuten MRET‑aktiviertes Medium).
Dieses Experiment zeigte auch den starken Effekt von MRET‑aktiviertem Wasser auf den Prozess der Teilung von E.coli‑Mikroorganismen, die Modifikation der Formen von Kulturzellen und die Größe der Kolonien. Es wurde beobachtet, dass einer der Gründe für das abnorm niedrige Wachstum von E.coli‑Bakterien mit der Modifikation des Prozesses der Zellteilung in MRET‑aktiviertem Nährmedium zusammenhängt. Im Prozess des Wachstums und der Vermehrung trennten sich eine große Anzahl von Zellen nicht voneinander und es bildeten sich lineare Aufstellungen bestehend aus 2‑3 sequentiell gepaarten Zellen. Die Kulturzellen, die in nicht‑aktiviertem und MRET‑aktiviertem Medium gewachsen sind, sind in Abb. 5 und Abb. 6 dargestellt.
 |
 |
| Abb. 5: Zellen von Escherichia coli K‑12 gewachsen in nicht‑aktiviertem Medium. | Abb. 6: Zellen von Escherichia coli K‑12 gewachsen in MRET‑aktiviertem Medium (tact =1 Stunde). |
II. Der Effekt von MRET Wasser auf die metabolische Aktivität von E.coli‑Bakterien in aerober und anaerober Umgebung
Reduktionsaktivität ist eine integrale Charakteristik der metabolischen Aktivität von Mikroorganismen und wird mit Hilfe des Natrium‑Resazurin‑Farbindikators im prozentualen Grad der Entfärbung gemessen (lila = 0%, rot = 50%, transparent = 100%). Die Reduktionsaktivität von E.coli‑Bakterien reduzierte sich bis zu 3 Mal in 30 Minuten MRET‑aktiviertem Wasser und bis zu 1,6 Mal in 60 Minuten aktiviertem Wasser während der ersten 6 Stunden des Experiments in aerober Umgebung (Abb. 7 und 8).
 |
 |
| K – Kontrolle; 0,5 – 0,5 Stunde MRET‑aktiviertes Wasser; 1,0 – 1 Stunde MRET‑aktiviertes Wasser |
|
| RC = 0,2, R0,5 = 0,1, R1,0 = 0,4 K0,5 = 0,5, K1,0 = 2,0 DC = D0,5 = D1,0 |
RC = 25, R0,5 = 9, R1,0 = 19 K0,5 = 0,36, K1,0 = 0,76 DC = D0,5 = D1,0 |
Abb. 7: Vergleichender Test der metabolischen (Reduktions‑) Aktivität von E.coli (Kontrollproben, 30 und 60 Minuten MRET‑aktiviertes Wasser) in aerober Umgebung: R — Reduktionsaktivität (in Kontrolle, 0,5 Stunde und 1,0 Stunde MRET‑aktiviertes Wasser), K — relative Reduktionsaktivität, D — optische Dichte.
Relative Reduktionsaktivität von E.coli‑Bakterien in aerober Umgebung
Abb. 8: Relative Reduktionsaktivität von E.coli in MRET Wasser aktiviert für 0,5 Stunde (K0,5=R0,5/RC — rote Farbe) und für 1,0 Stunde (K1,0=R1,0/RC — grüne Farbe) im Vergleich zu Kontrollproben ohne Aktivierung (KC=1 — blaue Farbe) in aerober Umgebung.
Dieses Experiment zeigte, dass es keine direkte Korrelation zwischen der Hemmung der metabolischen (Reduktions‑) Aktivität und der Hemmung des Wachstums von E.coli (bakteriostatische Aktivität) in MRET aktiviertem Wasser gab. Der bakteriostatische Effekt ist substantiell höher in 60 Minuten aktiviertem Wasser und die Hemmung der Reduktionsaktivität während der ersten 3 Stunden ist höher in 30 Minuten aktiviertem Wasser. Somit zeigte dieses Experiment, dass die optimale Aktivierungszeit für die maximale Hemmung der metabolischen Aktivität von E.coli‑Bakterien in aerober Umgebung 30 Minuten ist. Die gleiche optimale Aktivierungszeit wurde im Prozess einer anderen Untersuchung bezüglich der Anwendung von MRET aktiviertem Wasser zur präventiven Behandlung und Verbesserung der Tumorresistenz in vivo an 500 Mäusen für zwei Arten von Krebs gefunden, die am Kiewer Institut für Experimentelle Pathologie, Onkologie und Radiobiologie der Ukrainischen Akademie der Wissenschaften durchgeführt wurde.
Unter Berücksichtigung, dass eine kleine Population von pathogenen Bakterien, wie E.coli, normalerweise in komplexen mikrobiellen Assoziationen im Darm des Körpers vorhanden ist, wurde der Test der metabolischen Aktivität von E.coli‑Bakterien in anaerober Umgebung durchgeführt. Anaerobe Umgebung simuliert die Umweltbedingungen ähnlich den Bedingungen im Darm von Menschen und Tieren. Die Untersuchung zeigte, dass die Reduktionsaktivität von E.coli‑Bakterien in anaerober Umgebung praktisch nicht veränderte (Abb. 9 und 10).
K — Kontrolle; 0,5 — 0,5 Stunde MRET‑aktiviertes Wasser; 1,0 — 1 Stunde MRET‑aktiviertes Wasser; KSTER — Referenz zur Sterilität
Abb. 9: Vergleichender Test der metabolischen (Reduktions‑) Aktivität von E.coli (Kontrollproben, 0,5 Stunde und 1,0 Stunde MRET‑aktiviertes Wasser, KSTER — Referenz zur Sterilität) in anaerober Umgebung: R — Reduktionsaktivität (in Kontrolle, 0,5 Stunde und 1,0 Stunde MRET‑aktiviertes Wasser), K — relative Reduktionsaktivität, D — optische Dichte, V — Gasvolumen in den Flaschen.
Reduktionsaktivität von E.coli‑Bakterien in anaerober Umgebung
Abb. 10: Reduktionsaktivität von E.coli in 30 und 60 Minuten MRET‑aktiviertem Wasser und in Kontrollproben ohne Aktivierung (R0,5 — rote Farbe, R1,0 — grüne Farbe, RC — blaue Farbe) in anaerober Umgebung.
Dieses Experiment zeigte, dass der Prozess der MRET‑Aktivierung keinen signifikanten Effekt auf die Reduktionsaktivität von E.coli‑Bakterien in anaerober Umgebung hatte.
III. Der stimulierende Effekt von MRET Wasser auf die metabolische Aktivität von komplexen mikrobiellen Assoziationen in anaerober Umgebung
Um die Umweltbedingungen ähnlich den Bedingungen im Darm von Menschen und Tieren zu simulieren, wurde der Test der metabolischen Aktivität von mikrobiellen Assoziationen in anaerober Umgebung durchgeführt. Es wurde gefunden, dass MRET‑aktiviertes Wasser die Reduktionsaktivität von komplexen mikrobiellen Assoziationen während der ersten Stunden des Experiments substantiell erhöhte (Abb. 11).
1,0 — 1 Stunde MRET‑aktiviertes Wasser; 0,5 — 0,5 Stunde MRET‑aktiviertes Wasser; K — Kontrolle
Abb. 11: Vergleichender Test der metabolischen (Reduktions‑) Aktivität von mikrobiellen Assoziationen (1,0 Stunde und 0,5 Stunde MRET‑aktiviertes Wasser und Kontrollproben) in anaerober Umgebung: R — Reduktionsaktivität (in Kontrolle, 0,5 Stunde und 1,0 Stunde MRET‑aktiviertes Wasser), K — relative Reduktionsaktivität, V — Gasvolumen in den Flaschen.
Dieses Experiment zeigte, dass die optimale Zeit der Aktivierung für die maximale Erhöhung der metabolischen Aktivität von mikrobiellen Assoziationen in anaerober Umgebung 30 Minuten war. Die gleiche optimale Aktivierungszeit wurde im Prozess der Hemmung der metabolischen Aktivität von E.coli in aerober Umgebung und in einer anderen Untersuchung bezüglich der Anwendung von MRET aktiviertem Wasser zur präventiven Behandlung und Verbesserung der Tumorresistenz in vivo gefunden.
SCHLUSSFOLGERUNGEN
Diese Untersuchung zeigte, dass bei niedriger Anfangskonzentration von Zellen der bedingt pathogenen mikrobiologischen Kultur Escherichia coli K‑12 in wasserbasiertem Nährmedium, das für 30 Minuten und 60 Minuten aktiviert wurde, das Wachstum der Kultur 27 und 303 Mal während der 25 Stunden des Experiments in aerober Umgebung gehemmt wurde. Dieses Experiment zeigte auch den starken Effekt von MRET aktiviertem Wasser auf den Prozess der Teilung von E.coli‑Mikroorganismen, die Modifikation der Formen von Kulturzellen und die Größe der Kolonien. Es wurde beobachtet, dass einer der Gründe für das abnorm niedrige Wachstum der E.coli‑Population mit der Modifikation des Prozesses der Zellteilung in MRET‑aktiviertem Nährmedium zusammenhängt. Diese Ergebnisse erlauben anzunehmen, dass der Prozess der MRET‑Aktivierung und der Sterilisationseffekt von MRET Wasser in der Lebensmittelindustrie und zur Wasserreinigung angewendet werden kann.
Die zweite Stufe der Untersuchung zeigte, dass die metabolische (Reduktions‑) Aktivität von E.coli‑Bakterien sich bis zu 3 Mal in 30 Minuten aktiviertem Wasser und bis zu 1,6 Mal in 60 Minuten aktiviertem Wasser während der ersten 6 Stunden des Experiments in aerober Umgebung reduzierte. Ein anderes Experiment zeigte, dass der Prozess der MRET‑Aktivierung die Reduktionsaktivität von E.coli‑Bakterien in anaerober Umgebung nicht beeinflusste und folglich eine kleine Population von bedingt pathogenen Bakterien, wie E.coli, die normalerweise in mikrobiellen Assoziationen im Darm des Körpers vorhanden ist, nicht beeinflussen sollte.
Um die Umweltbedingungen ähnlich den Bedingungen im Darm von Menschen und Tieren zu simulieren, wurde der Test der metabolischen Aktivität von komplexen mikrobiellen Assoziationen in anaerober Umgebung durchgeführt. Es wurde entdeckt, dass der MRET‑aktivierte Prozess die Reduktionsaktivität von komplexen mikrobiellen Assoziationen während der ersten Stunden des Experiments substantiell erhöhte. Die gleiche 30 Minuten optimale Aktivierungszeit wurde im Prozess der Hemmung der metabolischen Aktivität von bedingt pathogenen E.coli‑Bakterien in aerober Umgebung und für die maximale Erhöhung der metabolischen Aktivität von komplexen mikrobiellen Assoziationen in anaerober Umgebung (vorhanden im Darm) beobachtet. Die vorherige Untersuchung bezüglich der Anwendung von MRET aktiviertem Wasser zur präventiven Behandlung und Verbesserung der Tumorresistenz in der Onkologie in vivo an 500 Mäusen zeigte auch die besten Ergebnisse bei 30 Minuten MRET‑aktiviertem Wasser. Somit zeigt diese Untersuchung, dass die Einnahme von MRET Wasser vorteilhaft für den Prozess der Verdauung ist und den Stoffwechsel des Körpers verbessern kann.
_______________________________________________________________________________________________
DER EFFEKT VON MRET AKTIVIERTEM WASSER AUF STAPHYLOKOKKEN‑INFEKTION IN VIVO IM TIERMODELL (AUF DEN ZELLEN DES IMMUNSYSTEMS) UND IN VITRO AUF DER KULTUR VON STAPHYLOCOCCUS AUREUS WOOD‑46
I. Der Effekt von MRET Wasser auf Staphylokokken‑Infektion in vivo im Tiermodell
Die Forschung wurde an der Kiewer Nationalen Schewtschenko‑Universität, Ukraine an 400 Mäusen durchgeführt. Es wurden männliche Mäuse der Linie BALB im Alter von 11 — 13 Wochen und mit einem Gewicht von 18 — 21 Gramm verwendet. Im Verlauf der Untersuchung wurden alle Mäuse in drei Gruppen eingeteilt. Vor der Inokulation der Staphylococcus aureus Wood‑46‑Kultur nahm eine Gruppe von Mäusen MRET Wasser während 4 Wochen zu sich (Gruppe 1), eine andere Gruppe nahm MRET Wasser während 2 Wochen zu sich (Gruppe 2), die Kontrollgruppe nahm nicht‑aktiviertes gewöhnliches destilliertes Wasser zu sich. Während der folgenden 2 Wochen des Experiments nahmen die ersten beiden Gruppen weiterhin MRET Wasser zu sich und die Kontrollgruppe nahm gewöhnliches destilliertes Wasser zu sich. Die erste Reihe von Experimenten wurde an 225 Mäusen durchgeführt, um die Persistenz des Pathogens in Homogenat von Nieren von Mäusen zu analysieren, wobei 5 Gruppen von Mäusen verglichen wurden (zwei Gruppe 1 und zwei Gruppe 2 mit 15 Minuten und 30 Minuten MRET aktiviertem Wasser und Kontrolle). Nach vorläufigen Experimenten wurde das optimale 30 Minuten MRET aktivierte Wasser (destilliert) für die Hauptreihe der Untersuchung gewählt.
ERGEBNISSE:
1. Signifikante schützende Eigenschaften von MRET Wasser.
Die signifikanten schützenden Eigenschaften von MRET Wasser wurden durch eine substantielle Abnahme von Staphylococcus CFU (koloniebildende Einheiten) in Homogenat von Nieren von Mäusen auf MRET Wasser im Vergleich zur Kontrollgruppe von Mäusen nach der intra‑peritonealen Staphylokokken‑Infektion nach den ersten 24 Stunden bestätigt. Die Analyse der Daten zu Beginn der Experimente führt zu der Schlussfolgerung, dass die signifikante Abnahme der Pathogenkolonien in Homogenat von Nieren von Mäusen auf MRET Wasser erst nach 24 Stunden nach der Inokulation der Staphylococcus‑Kultur beginnt. Die Ergebnisse bei 30 Minuten aktiviertem Wasser waren viel besser als bei 15 Minuten aktiviertem Wasser und alle weiteren Experimente wurden mit 30 Minuten aktiviertem Wasser durchgeführt.
2. Der Konsum von MRET Wasser eliminierte die Todesrate von 30% (Kontrollgruppe) auf 0% (MRET‑Gruppe) während der ersten 9 Tage des Experiments.
Es gab keinen Fall von Tiersterben in allen untersuchten Gruppen innerhalb der ersten 24 Stunden nach intra‑peritonealer Inokulation der Staphylococcus‑Kultur, was ein ziemlich standardmäßiges Ergebnis ist. Während der nächsten 8 Tage starben 30% der Tiere in der Kontrollgruppe, was ebenfalls ein standardmäßiges Ergebnis ist. Aber es gab keine Todesfälle in beiden Gruppen von Mäusen, die MRET aktiviertes Wasser zu sich nahmen, und das ist ein bemerkenswertes Ergebnis. Dennoch manifestieren sich die Hauptfolgen der Staphylococcus‑Infektion nicht im Tod von Tieren wie im Fall von onkologischen Erkrankungen. Das Staphylococcus‑Virus beeinflusst die lebenden Systeme und Organe des Körpers. Diese pathogenen Mikroorganismen verursachen Entzündungen, Eiterungen, Abszesse, Furunkel, Angina, septische Zustände usw. Deshalb wurde eine detaillierte Untersuchung des Prozesses der Stimulation durch MRET Wasser von Phagozyten und von lymphoiden Organen des Immunsystems von Mäusen, die mit Staphylococcus aureus‑Kultur infiziert waren, durchgeführt und ist in diesem Bericht dargestellt.
3. Die Entwicklung der lokalen akuten Entzündung wird im Fall der Einnahme von MRET aktiviertem Wasser wesentlich unterdrückt.
Die lokale Entzündung wurde mit Hilfe der Inokulation der Staphylococcus aureus‑Kultur in die hintere linke Pfote induziert. Die gewöhnliche entzündliche Reaktion wurde in der Gruppe von Mäusen auf nicht‑aktiviertem Wasser beobachtet: die intensive Rötung der hinteren linken Pfote (Abb. 1). Beide Gruppen von Mäusen auf MRET Wasser entwickelten keine Rötung der hinteren linken Pfote, die mit Staphylococcus aureus‑Kultur inokuliert wurde (Abb. 2). Die Ergebnisse dieses Experiments bestätigen die Tatsache der substantiellen Hemmung der entzündlichen Infektion im Fall des regelmäßigen Konsums von MRET Wasser.
 |
 |
| Abb. 1: Die Ansicht der Pfoten einer Maus auf nicht‑aktiviertem Wasser (Rötung der injizierten Pfote) 24 Stunden nach der Injektion der Staphylococcus‑Kultur. | Abb. 2: Die Ansicht der Pfoten einer Maus auf MRET aktiviertem Wasser (keine Rötung der injizierten Pfote) 24 Stunden nach der Injektion der Staphylococcus‑Kultur. |
4. Der Konsum von MRET Wasser stimuliert die Aktivität des phagozytischen Systems und das Niveau der natürlichen Resistenz von Tieren gegenüber pathogenen Mikroorganismen.
Für die folgende Reihe von Experimenten wurde die Inokulation von Staphylococcus aureus Wood‑46 intra‑peritoneal in Dosis LD30 durchgeführt, um die Infektion über den gesamten Körper zu verbreiten.
Das phagozytische System ist einer der Hauptfaktoren der natürlichen nicht‑spezifischen zellulären Resistenz gegenüber Infektionen und Entzündungen. Es ist die erste Verteidigungslinie eines Organismus gegen das Eindringen und die Vermehrung von pathogenen Mikroorganismen. Die schützende Rolle von phagozytischen Zellen basiert auf ihrer Fähigkeit, fremde Agenten zu identifizieren, zu verschlingen und zu nutzen, die in die innere Umgebung eines Makroorganismus eingedrungen sind. Phagozytose ist der Hauptmechanismus der natürlichen Resistenz, besonders im ersten Stadium des ansteckenden Prozesses; es ist ein regelmäßiger Teil der Bildung der spezifischen Immunantwort.
Die häufigste Methodik, die in den Studien der funktionellen Aktivität von Phagozyten angewendet wird, ist die Untersuchung ihrer phagozytischen (Verschlingung von fremden Zellen) und sauerstoffabhängigen bakteriziden Aktivität. Die phagozytische Aktivität von Neutrophilen und Makrophagen wird basierend auf dem Phagozytose‑Index (Prozentsatz der Phagozyten, die Test‑Bakterien verschlungen haben) und auf der Phagozytose‑Zahl (durchschnittliche Anzahl von Test‑Bakterien, die von einem Phagozyten verschlungen wurden) geschätzt. Die Kulturen von Staphylococcus aureus und Latex werden gewöhnlich als Test‑Bakterien verwendet. Die sauerstoffabhängige bakterizide Aktivität von Phagozyten wird mit Hilfe des NBT‑Tests studiert: eine sauerstoffabhängige Reduktion von Nitro Blue Tetrazolium in ein unlösliches Diformazan von Nitro Blue Tetrazolium‑Derivat durch Phagozyten. Mit Hilfe des NBT‑Tests ist es möglich, die aktivierten Phagozyten von den nicht‑aktivierten zu unterscheiden.
MRET Wasser stimulierte die phagozytischen Kapazitäten von Neutrophilen des peripheren Blutes und peritonealer Makrophagen, indem es ihre phagozytische Aktivität erhöhte, besonders Phagozytose‑Indizes (Abb. 3A) und Phagozytose‑Zahl (Abb. 3B). Es stimulierte auch ihre sauerstoffabhängige bakterizide Aktivität, besonders die Erhöhung der Anzahl von NBT‑positiven Phagozyten (Abb. 4).
Abb. 3A: Phagozytose‑Index von Neutrophilen und Makrophagen in zwei Wochen des Experiments (Objekt der Phagozytose - Staphylococcus aureus): 1 — Kontrollgruppe; 2 — Mäuse auf MRET Wasser (präventiv für 4 Wochen); 3 — Mäuse auf MRET Wasser (präventiv für 2 Wochen).
Abb. 3B: Phagozytose‑Zahl von Neutrophilen und Makrophagen in zwei Wochen des Experiments (Objekt der Phagozytose — Staphylococcus aureus): 1 — Kontrollgruppe; 2 — Mäuse auf MRET Wasser (präventiv für 4 Wochen); 3 — Mäuse auf MRET Wasser (präventiv für 2 Wochen).
Abb. 4: Sauerstoffabhängige bakterizide Aktivität (NBT‑Test) von Neutrophilen und Makrophagen in zwei Wochen des Experiments:
1 — Kontrollgruppe; 2 — Mäuse auf MRET Wasser (präventiv für 4 Wochen); 3 — Mäuse auf MRET Wasser (präventiv für 2 Wochen).
Diese Experimente bestätigten die Erhöhung der effektiven Potenziale von Phagozyten, die einen der Hauptfaktoren der natürlichen Schutz eines Organismus darstellen und die Immunantwort initiieren.
Die Analyse der Daten zu Beginn der Experimente führt zu der Schlussfolgerung, dass die signifikante Intensivierung der phagozytischen und bakteriziden Aktivität von Makrophagen und Neutrophilen von Mäusen auf MRET Wasser erst nach 24 Stunden nach der intra‑peritonealen Inokulation der Staphylococcus‑Kultur beginnt. Am Ende von zwei Wochen des Experiments erhöhten sich die Mittelwerte der studierten Parameter in beiden Gruppen von Mäusen auf MRET Wasser substantiell im Vergleich zur Kontrollgruppe. Die Unterschiede in den Mittelwerten der Parameter der funktionellen Aktivität von Phagozyten der Gruppen von Mäusen, die MRET Wasser konsumierten, im Vergleich zur Kontrollgruppe von Mäusen auf nicht‑aktiviertem Wasser waren statistisch signifikant mit p<0,05 (für Phagozytose‑Index und NBT‑Test). Diese Ergebnisse bestätigen die signifikante Intensivierung der phagozytischen und bakteriziden Aktivität und der Immunsystemantwort nach dem Konsum von MRET Wasser.
Die Unterschiede in den Mittelwerten der studierten Parameter für die Gruppen von Mäusen auf MRET Wasser im Vergleich zueinander waren statistisch insignifikant, was die Ähnlichkeit des Niveaus der vorteilhaften Wirkung von MRET Wasser in beiden Gruppen bestätigt. Diese Tatsache bestätigt auch, dass der regelmäßige Konsum von MRET Wasser gesundheitliche Vorteile in ziemlich kurzer Zeit (2 Wochen im Fall des Tiermausmodells) bietet.
5. Der Konsum von MRET Wasser erhöht substantiell die Immunaktivität von lymphoiden Organen.
Am Ende einer anderen Reihe von Experimenten wurde in beiden Gruppen von Mäusen auf MRET Wasser eine substantielle statistisch signifikante (p<0,05) Erhöhung des Gewichts und der Zellularität (Anzahl von Zellen) einer Milz und Lymphknoten sowie die insignifikante Erhöhung des Gewichts und der Zellularität des Thymus beobachtet (Abb. 5 und Abb. 6).
Abb. 5: Das Gewicht von lymphoiden Organen in zwei Wochen des Experiments: 1 — Kontrollgruppe; 2 — Mäuse auf MRET Wasser (präventiv für 4 Wochen); 3 — Mäuse auf MRET Wasser (präventiv für 2 Wochen).
Abb. 6: Die Zellularität von lymphoiden Organen in zwei Wochen des Experiments: 1 — Kontrollgruppe; 2 — Mäuse auf MRET Wasser (präventiv für 4 Wochen); 3 — Mäuse auf MRET Wasser (präventiv für 2 Wochen).
Diese Ergebnisse bestätigen die Tatsache der signifikanten Intensivierung der Immunsystemantwort in Tieren auf MRET Wasser, die einer Staphylococcus‑Infektion ausgesetzt sind. Der Unterschied in den studierten Parametern zwischen den Gruppen von Mäusen auf MRET Wasser (4 Wochen und 2 Wochen präventiver Konsum von MRET Wasser) war insignifikant, was die ziemlich schnelle vorteilhafte Wirkung von MRET Wasser auf die Immunaktivität von lymphoiden Organen bestätigt.
Zu Beginn des Experiments zeigten die Zellularität und das Gewicht von lymphoiden Organen in MRET‑Gruppen keine deutliche Tendenz zu Modifikationen. Es ist vernünftig anzunehmen, dass der Konsum von MRET Wasser das Gewicht und die Zellularität von lymphoiden Organen nur während der Infektionsperiode beeinflusst.
SCHLUSSFOLGERUNGEN:
Der Konsum von MRET aktiviertem Wasser erhöht signifikant die Faktoren der natürlichen Resistenz des Körpers, die die erste Verteidigungslinie eines Organismus gegen das Eindringen und die Vermehrung von pathogenen Mikroorganismen darstellen.
Die Analyse der Daten zu Beginn des Experiments führt zu der Schlussfolgerung, dass signifikante Änderungen in allen studierten Parametern von Mäusen auf MRET Wasser (Abnahme der Pathogenkolonien in Homogenat von Nieren, Erhöhung des Gewichts und der Zellularität von lymphoiden Organen, Intensivierung der phagozytischen und bakteriziden Aktivität von Makrophagen und Neutrophilen) erst nach 24 Stunden nach der Inokulation der Staphylococcus‑Kultur beginnen. Mit anderen Worten erhöht der Konsum von MRET Wasser die Potenziale der Immunkapazitäten des Körpers, um Infektionen entgegenzuwirken, ohne Änderungen in den vitalen Parametern von Immunorganen und ‑funktionen vor dem Eindringen von infektiösen Pathogenen in den Körper.
Am Ende von zwei Wochen des Experiments erhöhten sich die Mittelwerte der studierten Parameter in beiden Gruppen von Mäusen auf MRET Wasser (präventiv für 4 und 2 Wochen respectively) signifikant im Vergleich zur Kontrollgruppe. Die Unterschiede in den Mittelwerten der studierten Parameter der Gruppen von Mäusen, die MRET Wasser konsumierten, im Vergleich zur Kontrollgruppe von Mäusen auf nicht‑aktiviertem Wasser waren statistisch signifikant mit p<0,05 (für die meisten der Parameter). Diese Ergebnisse bestätigen die signifikante Intensivierung der phagozytischen Aktivität und der Immunsystemantwort nach dem Konsum von MRET Wasser.
Die Unterschiede in den Mittelwerten der studierten Parameter für die Gruppen von Mäusen auf MRET Wasser im Vergleich zueinander waren statistisch insignifikant, was die Ähnlichkeit des Niveaus der vorteilhaften Wirkung von MRET Wasser in beiden Gruppen bestätigt. Diese Tatsache bestätigt auch, dass der regelmäßige Konsum von MRET Wasser gesundheitliche Vorteile in ziemlich kurzer Zeit (2 Wochen im Fall des Tiermausmodells) bietet.
II. Der Effekt von MRET‑Aktivierung auf den Prozess des Wachstums von Staphylokokken‑Kultur in Nährmedium
Die folgenden Experimente wurden entworfen, um den Effekt der MRET‑Aktivierung auf den Prozess des Wachstums und der Entwicklung von Staphylococcus aureus Wood‑46‑Kultur in vitro in Nährmedium (MPA — Fleisch‑Pepton‑Agar) zu studieren. Die bakterielle Kultur wurde über Nacht bis zur stationären Phase gewachsen und dann auf MPA in Form von Suspension bei verschiedenen Inokulationsdichten ausplattiert. Das MPA mit Kultur wurde MRET‑aktiviert während verschiedener Zeiträume (Aktivierung für 15 Minuten, 30 Minuten, 45 Minuten und 60 Minuten respectively) unter den Anforderungen der Sterilität. Petrischalen mit aktiviertem und nicht‑aktiviertem Medium (MPA mit Kultur) wurden mit Glaskappen bedeckt (aerobe Umgebung) und in den Thermostaten für Kultivierung bei einer Temperatur von 37oC während 18‑24 Stunden gestellt.
Nach der Kultivierung wurden die morphologischen und tinctoriellen Eigenschaften von Kulturen beobachtet und die Zahlen der auf MPA gewachsenen Kolonien gezählt. Die bakteriostatische Aktivität von MRET‑aktiviertem Nährmedium (MPA) wurde als Index der bakteriostatischen Aktivität (IBA) gemessen. Ein Index der bakteriostatischen Aktivität ist definiert als ein Koeffizient der Hemmung des Wachstums und der Vermehrung von Pathogenen in bakteriostatischem Medium, besonders in MRET‑aktiviertem Nährmedium. Es wird berechnet als Reduktion der Anzahl von Kolonien (CFU — Koloniebildende Einheiten) in MRET‑aktiviertem Medium bezogen auf die Kontrollproben, die nicht der Aktivierung ausgesetzt waren:
IBA = (NKontrolle — Nakt)/NKontrolle
wo N — Anzahl von Bakterienkolonien (CFU) in Kontrolle (nicht‑aktiviert) und MRET‑aktiviertem Nährmedium, respectively.
wo N — Anzahl von Bakterienkolonien (CFU) in Kontrolle (nicht‑aktiviert) und MRET‑aktiviertem Nährmedium, respectively.
Um die Sterilität der Experimente zu verifizieren, wurden Petrischalen mit Nährmedium (MPA) ohne Staphylokokken‑Kultur dem Prozess der Aktivierung ausgesetzt und dann im Thermostaten gehalten. Es wurden keine Kolonien von Kultur beobachtet, was die Sterilität der Umgebung bestätigt.
ERGEBNISSE:
Nach der Untersuchung wurde die direkte Korrelation zwischen Aktivierungszeiten (tact), Anfangskonzentrationen von Staphylokokken‑Kultur (N0) und einer Anzahl von Kolonien, die auf MRET‑aktiviertem Medium gewachsen sind, beobachtet. Die Ergebnisse sind unten in Form einer Reihe von Fotos von Petrischalen mit den auf MPA‑Oberflächen gewachsenen Kolonien und den folgenden Diagrammen basierend auf den Daten dieser Experimente dargestellt (Abb. 7 — 12).
Im Prozess der Untersuchung wurde der Effekt der MRET‑Aktivierung auf das Wachstum von Staphylokokken‑Kultur bei ziemlich kleiner Anfangskonzentration von Pathogenen analysiert. Die Daten entsprechend höheren Anfangskonzentrationen N0 > 103 Bakterien/ml wurden nicht analysiert aufgrund der Schwierigkeiten bezogen auf die Berechnung von sehr hohen Werten einer Anzahl von Kolonien, trotz der Tatsache der hohen bakteriostatischen Aktivität von MRET‑aktiviertem Nährmedium im Fall von hohen Anfangskonzentrationen.
Die hochsignifikante bakteriostatische Wirkung von 92 — 93% wurde nach MRET‑Aktivierung für 30 Minuten und mehr von Kulturen mit Anfangskonzentration N0 = 103 Bakterien/ml (Abb. 7 und 8) und von 70 — 90% mit Anfangskonzentration von N0 = 102 Bakterien/ml (Abb. 9 und 10) beobachtet. Im Fall von Kulturen mit niedriger Anfangskonzentration N0 = 10 Bakterien/ml übertraf die bakteriostatische Aktivität in 15 Minuten aktiviertem Nährmedium 93% und in 30 Minuten aktiviertem Nährmedium wurde 100% Hemmung von Staphylokokkenkolonien beobachtet (Abb. 11 und 12).
.jpg) |
.jpg) |
| N0 = 103 Bakterien/ml, Kontrolle | N0 = 103 Bakterien/ml, takt = 15 min |
.jpg) |
 |
| N0 = 103 Bakterien/ml, takt = 30 min | N0 = 103 Bakterien/ml, takt = 45 min |
 |
|
| N0 = 103 Bakterien/ml, takt = 60 min |
Abb. 7: Der Effekt der Zeitdauer der MRET‑Aktivierung auf die Hemmung des Wachstums von Kultur von Staphylococcus aureus Wood‑46 mit Anfangskonzentration von Kultur N0 = 103 Bakterien/ml.
Abb. 8: Der Effekt der Zeitdauer der MRET‑Aktivierung auf die Hemmung des Wachstums von Kultur von Staphylococcus aureus Wood‑46 mit Anfangskonzentration von Kultur N0 = 103 Bakterien/ml. IBA — Index der bakteriostatischen Aktivität (Reduktion der Anzahl von Kolonien bezogen auf die Kontrollproben, die nicht der Aktivierung ausgesetzt waren).
 |
|
| N0 = 102 Bakterien/ml, Kontrolle | N0 = 102 Bakterien/ml, takt = 15 min |
.jpg) |
.jpg) |
| N0 = 102 Bakterien/ml, takt = 30 min | N0 = 102 Bakterien/ml, takt = 45 min |
.jpg) |
|
| N0 = 102 Bakterien/ml, takt = 60 min |
+
Abb. 9: Der Effekt der Zeitdauer der MRET‑Aktivierung auf die Hemmung des Wachstums von Kultur von Staphylococcus aureus Wood‑46 mit Anfangskonzentration von Kultur N0 = 102 Bakterien/ml.
Abb. 9: Der Effekt der Zeitdauer der MRET‑Aktivierung auf die Hemmung des Wachstums von Kultur von Staphylococcus aureus Wood‑46 mit Anfangskonzentration von Kultur N0 = 102 Bakterien/ml.
Abb. 10: Der Effekt der Zeitdauer der MRET‑Aktivierung auf die Hemmung des Wachstums von Kultur von Staphylococcus aureus Wood‑46 mit Anfangskonzentration von Kultur N0 = 102 Bakterien/ml. IBA — Index der bakteriostatischen Aktivität (Reduktion der Anzahl von Kolonien bezogen auf die Kontrollproben, die nicht der Aktivierung ausgesetzt waren).
|
 |
| N0 = 10 Bakterien/ml, Kontrolle | N0 = 10 Bakterien/ml, takt = 15 min |
Abb. 11: Der Effekt der Zeitdauer der MRET‑Aktivierung auf die Hemmung des Wachstums von Kultur von Staphylococcus aureus Wood‑46 mit Anfangskonzentration von Kultur N0 = 10 Bakterien/ml.
Abb. 12: Der Effekt der Zeitdauer der MRET‑Aktivierung auf die Hemmung des Wachstums von Kultur von Staphylococcus aureus Wood‑46 mit Anfangskonzentration von Kultur N0 = 10 Bakterien/ml. IBA — Index der bakteriostatischen Aktivität (Reduktion der Anzahl von Kolonien bezogen auf die Kontrollproben, die nicht der Aktivierung ausgesetzt waren).
SCHLUSSFOLGERUNGEN:
1. MRET‑Aktivierung des wasserbasierten Nährmediums mit suspendierter Staphylokokken‑Kultur führt zur Entstehung hoher bakteriostatischer Aktivität von Nährmedium, die von der Zeitdauer der Aktivierung und Anfangskonzentration von Kulturzellen abhängt.
2. Die bakteriostatische Aktivität erhöht sich mit der Erhöhung der Aktivierungszeit (die Aktivierungszeiten bis zu 60 Minuten wurden studiert).
3. Die Effizienz der bakteriostatischen Aktivität erhöht sich mit der Abnahme der Anfangskonzentration der Suspension von Staphylokokken‑Kultur. Der Prozess der MRET‑Aktivierung ist am effektivsten auf Kultursuspensionen mit der Konzentration nicht mehr als 103 Bakterien/ml.
4. Die Ergebnisse der Untersuchung liefern Beweise bezüglich der hohen Effizienz der MRET‑Aktivierung auf die Hemmung des Wachstums von Kolonien und Vermehrung von Staphylokokken‑Mikroorganismen in vitro. Diese Ergebnisse erlauben anzunehmen, dass der Prozess der MRET‑Aktivierung und der Sterilisationseffekt von MRET Wasser in der Lebensmittelindustrie und zur Wasserreinigung angewendet werden kann.
_______________________________________________________________________________________________
Live‑Blut‑Zellanalyse
In diesem speziellen Fall zeigt die Blutprobe des Probanden vor der Einnahme von aktiviertem Wasser freie Radikalangriffe auf Zellen. Beachten Sie die «stacheligen» Blutzellen, die fast 90% der Probe ausmachen. 30 Minuten später, nach der Einnahme von aktiviertem Wasser, zeigt die Blutprobe eine Umgebung ohne freie Radikale.
In diesem speziellen Fall zeigt die Blutprobe des Probanden vor der Einnahme von aktiviertem Wasser sogenannte Rouleau‑Bildung, wenn Blutzellen gestapelt sind und ein wurmähnliches Muster bilden. 30 Minuten später, nach der Einnahme von aktiviertem Wasser, brachen die meisten wurmähnlichen Muster auf und bildeten individuelle Muster von schön runden Kugeln.
_______________________________________________________________________________________________
_______________________________________________________________________________________________
MRET Wasser‑Effekt auf Samenkeimung und Wachstum von Pflanzen
Die Untersuchungen des Einflusses von MRET aktiviertem Wasser auf Pflanzen wurden während eines 3‑Monats‑Zeitraums am Kiewer Institut für Pflanzen‑Genetik der Ukrainischen Akademie der Wissenschaften unter der Aufsicht von Prof. V. Vysotskii, Kiewer Nationale Universität durchgeführt. MRET aktiviertes Wasser beschleunigte den Prozess der Samenkeimung mehrerer Pflanzen (besonders von Kohl, Kürbis, Stangenbohnen, Gartenrettich und Erbsen) und verbesserte ihren Wachstumszyklus.